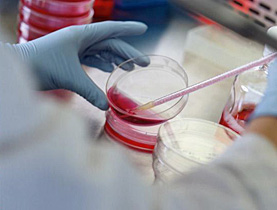

Roche grabs Genentech deal amid fusion frenzy
Swiss drug-makers Roche are set to add to the growing list of major takeovers in the pharmaceutical industry after thrashing out a deal to fully own Genentech.
Roche, which already owns 56 per cent of the biotech firm, will buy the remaining stake if Genentech shareholders end a protracted takeover battle by agreeing to a $46.8 billion (SFr54 billion) valuation.
News of the agreement between the two company boardrooms came after an unsuccessful Roche offer last year followed by a lower hostile bid in January. Fresh negotiations resulted in Genentech recommending the latest $95 per share offer on Thursday.
Roche shares rose slightly on the announcement with analysts praising the complete tie-up with the San Francisco-based biotech firm after an association between the two stretching back 18 years.
“Roche can now target complete commercial, production and research synergies,” Julius Bär analyst Christophe Eggmann told swissinfo. “The problem with holding a majority stake was that Roche could not exploit Genentech’s full potential.”
Big deals booming
Besides reaping full advantage of Genentech’s revenues, the takeover would also allow Roche to sidestep the need to renegotiate legal agreements on drug patent control that expire in a few years.
The latest big money pharmaceuticals deal comes at a time when the industry is awash with major takeovers. United States giant Pfizer agreed to buy rival Wyeth in January for $68 billion while Merck bid $41 billion for Schering-Plough last week.
The recent spate of consolidation has been widely interpreted as the answer to fundamental problems within the industry, most notably a widespread over-reliance on blockbuster drugs with diminishing patent protection rights.
Many firms are facing tough competition from cheaper generic copycat versions of these money-spinning products when patents expire, with fewer new drugs emerging from the pipeline to make up for lost revenues.
A global tightening of regulations has also made it harder and more expensive to get drugs onto the market, making cost-cutting synergies of research, production, sales and marketing more attractive.
“Short-term answer”
But Eggmann believes that major acquisitions cannot provide all of the answers and are not guaranteed to succeed.
“Mergers are one way to fix the problem in the short to medium-term, but longer-term the only solution is to generate new products and bring them onto the market,” he said.
“Size does not always matter. Glaxo merged with Smithkline to become the biggest pharmaceutical company in the world, but the results of the merger were very disappointing.”
However, the Genentech is a much better target, according to Eggmann, making its outright ownership a more attractive proposition for Roche. “Genentech is different as it has a healthy pipeline and scientific value,” he said.
That value is a prodigious amount of talented scientists and research success that Roche is determined to keep by allowing the biotech firm to keep its independence in the laboratory.
“It is good news that they have reached a friendly agreement because there is a better chance of securing the commitment of management and employees,” Eggmann added.
swissinfo, Matthew Allen
Roche, which was founded in 1896 in Basel, has core businesses in pharmaceuticals and diagnostics.
The group is the number one in the global diagnostics markets and is a leading supplier of medicines for cancer and transplantation.
Roche reported a profit of SFr11.4 billion ($10.44 billion) for 2007, beating analysts’ expectations.
Profit was up 25% on the preceding year. Turnover also grew 10% to SFr46.1 billion – the seventh consecutive year of double-digit growth.
Founded in 1976, San Francisco-based Genentech is today one of the world’s leading biotech companies.
The company specialises in oncology, immunology and tissue growth and repair treatments. It includes cancer drugs Avastin and Herceptin among its biggest selling products.
Genentech teamed up with Roche in 1990 in a $2.1 billion merger. Roche holds 55.9% of Genentech’s shares, giving the biotech company freedom to innovate.
In 2008, it was named as one of the 100 best companies to work for by Fortune magazine for the 10th year in a row.

In compliance with the JTI standards
More: SWI swissinfo.ch certified by the Journalism Trust Initiative
You can find an overview of ongoing debates with our journalists here . Please join us!
If you want to start a conversation about a topic raised in this article or want to report factual errors, email us at english@swissinfo.ch.